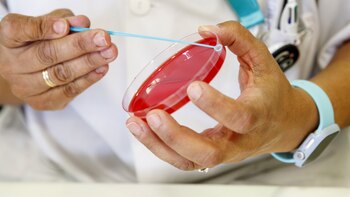
La OMS lanza CoViNet, una red global para el estudio de los coronavirus

La OMS lanza CoViNet, una red global para el estudio de los coronavirus
Logran una vacuna de polvo seco que se inhala una vez y previene el Covid-19 en animales

Últimas Noticias
El IBEX 35 baja un 0,75 % entre dudas sobre el devenir del conflicto en Oriente Medio
Alemania garantiza funcionamiento de refinería después de que Rusia cortara el suministro
Aseguran que Nicolás Larcamón no seguirá siendo técnico de Cruz Azul: hoy habrá una reunión con la directiva
La afición cementera ha manifestado su descontento con el técnico argentino a través de redes sociales
